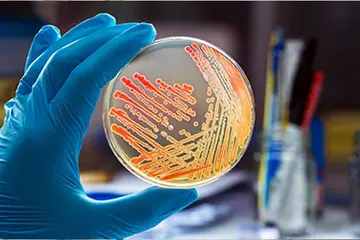

Reliable Microbiological,
Wet Lab, and Analytical Testing Services
We invest in the latest technologies, training and innovations to bring you the fastest turnaround time and competitive pricing in the Indian testing market

Assuring Quality testing solutions
across 8 Industry Verticals
We have a decade-long experience in laboratory business helping manufacturers and various organizations achieve quality and compliance

About Us
We Employ The Latest Research Technology with higher Precision
Established in the year 2020 in Chennai, Tamilnadu, India, Maeon Life Science Laboratories is an independent third-party testing laboratory approved by Tamilnadu Drug Control Department for testing Pharmaceuticals & Drugs (Form 37) and Cosmetics (Form COS 23). We serve a vast customer base ranging from small-scale to government and corporate sectors by delivering high quality, reliable and accurate test results with compliance to ISO/IEC 17025:2017. We are also approved by CDSCO (Form MD-40) for carrying out tests or evaluations of medical devices on behalf of the manufacturers under the Medical Devices Rules,2017.
We believe that our secret to success lies in
- Being customer-centric
- Uncompromising quality
- Fast turnaround time
- Nurturing our employees to learn and grow with us
500 +
scope
8 +
Industry verticals
10 +
team of Microbiologists, Biotechnologists & PhDs
10 +
Years Experience in Testing
OUR SERVICES
Explore Our Main Services
We are testing and consulting solution providers
Our microbiologists and biotechnologists focus their extreme curiosity on quality and compliance related challenges and draft a solution to help manufacturers to achieve compliance, provide testing solutions to be consistent with their quality assurance. We do this by
- Continuously upgrading our knowledge in regulatory changes in Indian and other markets
- Training our team in recent developments in test methods and protocols
- Upgrading our scope and consulting solutions in accordance with the market dynamics
10+ Years
Of Lab Experience
Call To Ask Any Questions